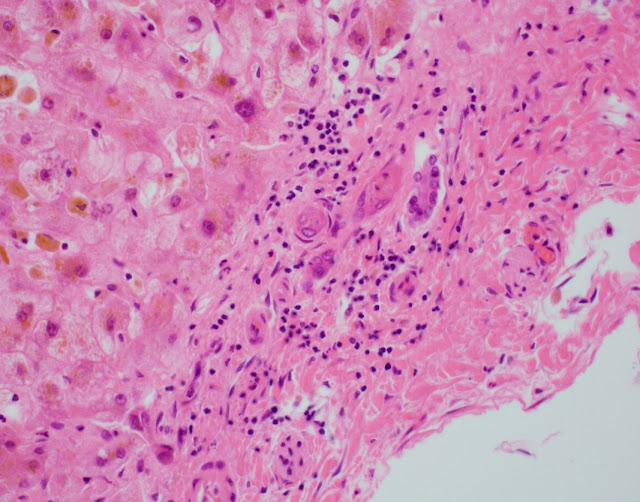
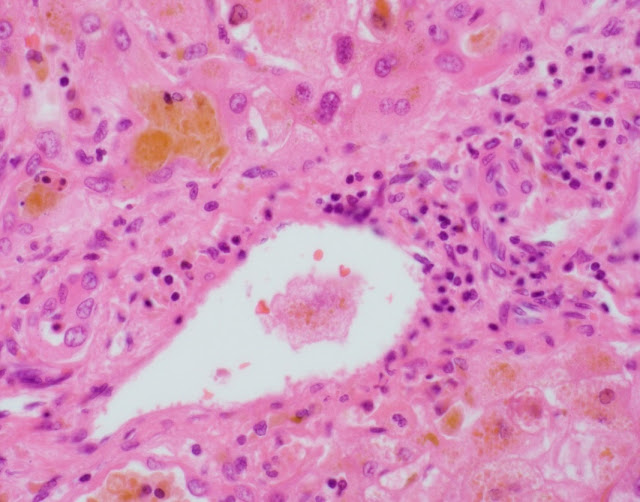

Interesting Case: July 2018
Case contributed by:
IvánGonzález, M.D., resident, Department of Pathology and Immunology, Washington University School of Medicine, St. Louis, MO
Deyali Chatterjee, M.D., Assistant Professor, Department of Pathology and Immunology, Washington University School of Medicine, St. Louis, MO
Clinical History
A 71-year-old man with a history of orthotopicliver transplant in 2013 secondary to idiopathic hepatic artery dissection (without previous episodes of acute cellular rejection) presented five years later with transaminitis and hyperbilirubinemia (AST 596 U/L, ALT 743 U/L, alkaline phosphatase 203 U/L), preceded by a viral-like illness. An extensive infectious work-up was negative, other than a CMV viremia of 6447 IU/mL by PCR, for which he was treated with valganciclovir. Liver biopsy showed a mixed portal infiltrate, bile duct injury without ductularreaction, lobular neutrophilic microabscesses, and zone 3 injury with dropout and hemorrhage. He was treated with prednisone without improvement. Over the next 5 months, he developed worsening liver failure (AST 107 U/L, ALT 201 U/L, alkaline phosphatase 88 U/L, total bilirubin 36.6 mg/dl, direct bilirubin 35 mg/dl) and renal failure, and underwent a second liver transplant (explant images shown here).
Imaging Findings
Computed tomography demonstrated an aneurysmal dilatation of the celiac artery with marked short segment narrowing of the origin of the common hepatic artery. ERCP did not reveal any biliary strictures.
IMAGES
MICROSCOPIC FINDINGS
The explant showed submassive hepatocellular necrosis with marked cholestasis, and markedly dystrophic changes in bile duct epithelium in the portal tracts, but there was no ductopenia. Ductular reaction was conspicuously absent. The portal tracts showed mild chronic inflammatory infiltrate, associated with mild focal endothelialitis, and reduced number of small arterial branches. Medium-sized bile ducts showed periductal fibrosis along with dystrophic epithelial changes. Large bile ducts showed foci of intraepithelial lymphocytes, and focal reactive changes. There was central perivenulitis, with foci of lobular microabscesses. There was no foam cell arterial lesion, fibro-muscular intimal thickening, or inflammatory infiltration of muscular arteries. Trichrome stain highlighted fine perisinusoidal fibrosis, extending to portal tracts, but there is no bridging fibrosis. Reticulin showed a largely preserved architecture. A cytomegalovirus immunostain was negative.
DIAGNOSIS
Histologic features of chronic rejection and ischemia.
DISCUSSION
We present an intriguing and unusual presentation of chronic rejection (CR).This challenging case was reviewed by several prominent pathologists within and outside our institution.
CRis an immune-mediated irreversible injury to the bile ducts, arteries and veins, that usually has an insidious onset and is often preceded by prior episodes of acute cellular rejection (ACR), that get progressively resistant to treatment. Nowadays less common with improved immunosuppression, another clinical setting includes a more acute presentation, with rapid progression of graft failure within a few weeks after transplantation. There can also be a late CR with insidious onset and indolent clinical course, without preceding ACR. The clinical course observed in our case, an accelerated clinical course although presenting late after transplantation (> 5 years), is therefore very unusual.
The histologic diagnostic features for CR include presence of dystrophic bile duct epithelium, bile duct loss, and foam cell obliterative arteriopathy. Some cases of late CR have also been reported to show chronic hepatitis-like changes. As has been described with acute presentations of chronic rejection, this case showed prominent inflammatory infiltrate, including endothelialitis and perivenulitis, which initially raised the histologic concern for acute rejection. The patient however remained unresponsive in spite of marked immunosuppressive therapy, and over time in the course of a few months, the inflammation reduced (reflected by the decrease in liver enzymes) whereas the bile duct dystrophy became more conspicuous, characteristically with no ductular reaction. With these clinical and histologic features, this was deemed as an unusual course of CR.
With the abnormal imaging and operative finding of the small caliber of proximal hepatic artery, and due to histologic overlap with CR, a component of ischemic cholangiopathy could not be entirely excluded.
LEARNING POINT
Although rare, acute presentation of chronic rejection can occur at any time interval after transplantation. Although cases of chronic rejection presenting acutely can show histologic overlap with acute cellular rejection especially early in the clinical course, dystrophic biliary epithelial changes, absence of ductular reaction, and unresponsiveness to immune suppressive therapy should indicate development of chronic rejection. Ductopenia or foam cell arteriopathy may not be seen in these cases which have an accelerated clinical course.
References
1- Burt A, Ferrell L, Hubscher S. MacSween’s Pathology of the Liver. 7thedition. Churchill Livingston Elsevier; 2018. Chapter 14, Transplantation Pathology.
2- Demetris A, Adams D, Bellamy C, et al. Update of the International Banff Schema for Liver Allograft Rejection: working recommendations for the histopathologic staging and reporting of chronic rejection. An International Panel. Hepatology 2000; 31(3): 792-799.
3- Blakomer K, Jain A, Ruppert K, et al. Chronic liver allograft rejection in a population treated primarily with tacrolimus as baseline immunosuppression: long-term follow-up and evaluation of features for histopathologic staging. Transplantation 2000; 69(11): 2330-2336.
4- Mourad M, Algarni A, Liossis C, Bramhall S. Aetiology and risk factors of ischaemic cholangiopathy after liver transplantation. World J Gastroenterol 2014; 20(20): 6159-6169.